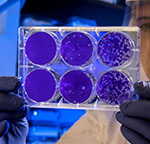
After staining the uninfected cells purple, the scientist will then count the clear spots on the plate, each representing a single virus particle. (Source: CDC PHIL.)

CDC Technology Transfer Office (TTO)
The Centers for Disease Control and Prevention Technology Transfer Office (TTO) partners with industry, academia, non-profits, and other government agencies to transfer CDC’s research portfolio into products and services to improve public health.
Interested in collaborating with CDC scientists? Visit our “For Industry” section to learn more about opportunities with CDC and find out how you can collaborate with CDC subject matter experts to help address unmet public health needs. CDC PHIL photo, Robert Denty.

CDC often facilitates solutions to unmet public health needs, by licensing or commercializing technologies. Here are a few ways CDC technologies have made an impact. CDC PHIL photo, James Gathany.

CDC News and Awards
- Sonic Healthcare USA to Begin Monkeypox Testing Today, Increasing Nationwide Testing Capacity
- Aegis Sciences to Begin Monkeypox Testing Today, Increasing Nationwide Testing Capacity | CDC Online Newsroom | CDC
- Quest Diagnostics to Begin Monkeypox Testing Today, Increasing Nationwide Testing Capacity
- Mayo Clinic Laboratories to Begin Monkeypox Testing Today, Increasing Nationwide Testing Capacity
- Rapid Diagnostic Testing for Response to the Monkeypox Outbreak — Laboratory Response Network, United States, May 17–June 30, 2022
- CDC Initiative Creates New Water Fluoridation Technology to Support Rural Health Needs
- FLC | Agencies Unite to Fight COVID-19 by Rapidly Sharing SARS-CoV-2 Virus Samples and Materials (federallabs.org)
- FLC | Trap to Control Mosquitoes that Spread Dengue and Other Viruses (federallabs.org)
Events
Our staff participate in various conferences. Please ask our team members about CDC’s technology, Small Business Innovation Research (SBIR) Program, and collaboration opportunities.
CDC photo, Office of Technology and Innovation.

CDC Researchers interested in reporting new inventions, developing collaborative partnerships with outside parties, and beginning new agreements can visit our “For CDC Researchers” section to find out how to get started with TTO staff assistance. Our Employee Discovery and Invention Report (EIR) form is located on CDC’s intranet. Search “TTO,” then look under “Quick Links.” We can gladly guide you through the process. CDC Photo, James Gathany.
Contact us with questions at TTO@CDC.gov.
